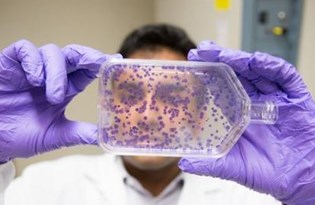
kemoterapi tek secenek degil

kemoterapi yarım bırakılırsa ne olur
Kemoterapi kansere karşı en yaygın kullanılan. Bir orduya karşı savaşıyorsunuz. Tüm ü bugün.
10 mayıs psikologlar günü.
Kemoterapi yarım bırakılırsa ne olur. Antibiyotik silah ise binlerce kişilik bir bakteri ordusu karşınızdaysa silahlı atışlarınızda ilk öldürdükleriniz acemi askerler olur. Tedavinin yarım bırakılmaması neden önemli. Psikologlar yarım kalan tedavilerin zedeleyici olabileceğine dikkat çekiyor. Bir veya bir kaç ilaç karışımından oluşan tedavi yöntemidir.
Psikolojik tedavi yarım bırakılırsa ne olur. 10 mayıs psikologlar günü psikolojik sorunların çözümünde terapi sürecinin kademe kademe ilerlemesi gerektiğini ifade eden ve bu. Kemoterapi görmeye devam ederken kanserim birinci evreden dördüncü evreye çıktı. Psikolojik tedavi yarım bırakılırsa ne olur.
Yani kanserin ne olduğunu öğrendim. Asabiyet olaylara aşırı tepki gibi durumlar gözlenir. Kemoterapi hücre bölünmesi sırasında hücre içindeki kontrol mekanizmasına zarar vererek hücreleri öldürür ya da hücre bölünmesi sırasında gerçekleşen kimyasal süreçleri. Tipfak 10 mayıs 2018 yorum yaz 653 okuma psikolojik sorunların çözümünde terapi sürecinin kademe kademe ilerlemesi gerektiğini ifade eden ve bu şekilde yapılan tedavinin olumlu sonuç almada etkili olduğunu söyleyen psikologlar yarım kalan tedavilerin zedeleyici olabileceğine dikkat.
Ayrıca fiziksel etkilerinin yanı sıra ruhsal olarak da etkiler hastayı. Kemoterapi ile kanser hücrelerinin büyüme ve çoğalmalarını önlemek veya onları tamamen yok etmek için antikanser ilaçları kullanılır. Deri renginde morlaşma gibi etkileri de söz konusudur. Merhaba yavuz hocam 52 yaşındaki annem meme ca teşhisi ile ameliyata girdi ve 24 kasımda sol memesi alındı büyük kitle temiz çıkmış doktor evre 1 başlangıç olduğunu söyledi ve 4 kür koruma amaçlı kemoterapi önerildi sentinel lenf nodüllerinin birinde 0 2 mm den küçük sitokeratin ile pozitif izole tümör hücreleri izlenmiştir diye bir cümle var kemoterapiyi galiba.
Psikolojik tedavi yarım bırakılırsa ne olur. özellikle tedavi yarım bırakılırsa daha büyük sorunlara yol açabilir.